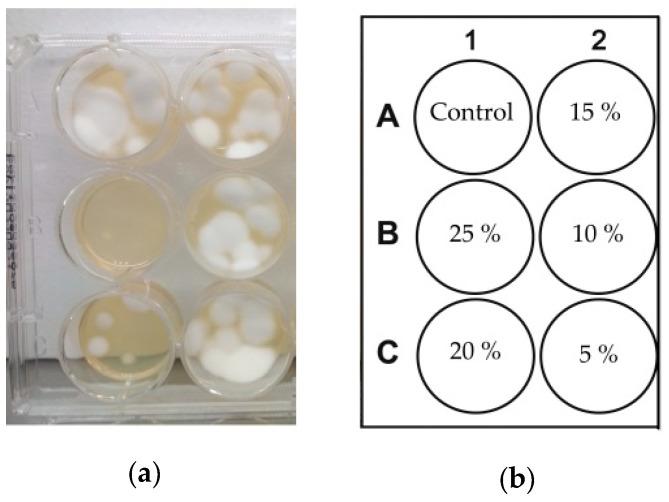

光动力根除……和…… (原文中“of”后面内容缺失)
Photodynamic Eradication of and .
作者信息
Valkov Anton, Zinigrad Michael, Nisnevitch Marina
机构信息
Department of Chemical Engineering, Ariel University, Kiryat-ha-Mada, Ariel 4070000, Israel.
出版信息
Pathogens. 2021 Feb 25;10(3):263. doi: 10.3390/pathogens10030263.
Conventional methods of onychomycosis treatment are ineffective in some cases because the cure of onychomycosis very often depends on the patient's individual response to the treatment; therefore, there is a crucial need to research and develop new methods of onychomycosis therapy. One of the most innovative treatments is photodynamic therapy (PDT) using photosensitizers (PSs). However, effective treatment depends on the correct choice of photosensitizer and substances that improve the characteristics of the final formulation. The aim of our work was to find an effective formulation for the treatment of onychomycosis. To achieve this goal, we tested the effect of three types of PSs, rose Bengal (RB), malachite green oxalate (MGO), and methylene blue (MB), on . The most effective PS was RB, and so the study was continued with . Additional comparative studies were carried out on substances included in the formulation (urea and thiourea), focusing on their antifungal activity, which can improve penetration through the nail plate. The composition of the formulation that achieved 100% eradication of under our conditions consisted of 150 μM RB, 5% urea, and 0.5% thiourea in glycerol/water (70/30%, /) solution. A white luminescent lamp was used as a light source (1.9 ± 0.1 mW cm). Stability of the formulation was checked. The selected formulation shows potential for future simplification and acceleration of PDT treatment of onychomycosis.
在某些情况下,传统的甲癣治疗方法无效,因为甲癣的治愈往往取决于患者对治疗的个体反应;因此,迫切需要研究和开发新的甲癣治疗方法。最具创新性的治疗方法之一是使用光敏剂(PSs)的光动力疗法(PDT)。然而,有效的治疗取决于光敏剂和能改善最终制剂特性的物质的正确选择。我们工作的目的是找到一种治疗甲癣的有效制剂。为实现这一目标,我们测试了三种类型的光敏剂,即孟加拉玫瑰红(RB)、草酸孔雀绿(MGO)和亚甲蓝(MB)的效果。最有效的光敏剂是RB,因此研究继续使用它。对制剂中包含的物质(尿素和硫脲)进行了额外的比较研究,重点关注它们的抗真菌活性,其可以改善通过甲板的渗透。在我们的条件下实现100%根除[此处原文缺失具体被根除的对象]的制剂组成包括在甘油/水(70/30%,v/v)溶液中的150μM RB、5%尿素和0.5%硫脲。使用白色发光灯作为光源(1.9±0.1 mW/cm²)。检查了制剂的稳定性。所选制剂显示出未来简化和加速甲癣光动力治疗的潜力。